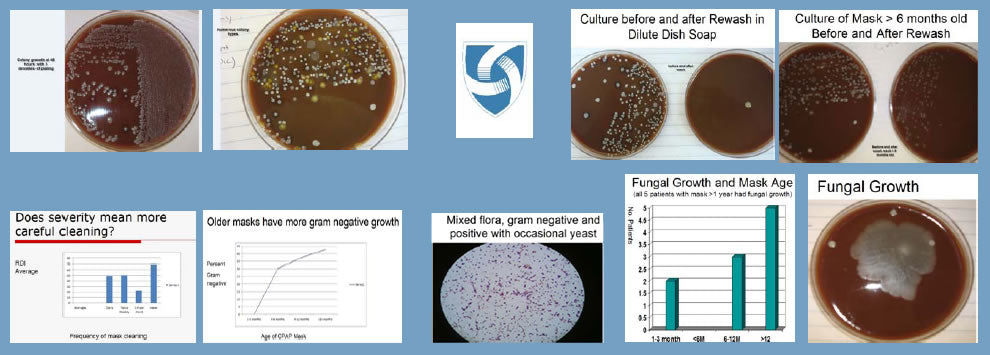
Everything you need to know about cleaning your CPAP equipment

To clean or not to clean, that is the question.
Just kidding.
Definitely "To clean" would be the way to go. But how important is it? How do I properly clean my equipment? and what happens if I don't clean the CPAP machine and accessories? And do I need a cleaning machine?

How important is cleaning for my CPAP device?

I am sure now you are aware that the most deadly and communicable diseases are ones that the naked eye cannot see. COVID-19 definitely was an eye opener for many. Although we cannot generally see them, bacteria, fungi and viruses can and will accumulate in the CPAP mask, CPAP tubing and CPAP Humidifier. Functionality wise, the CPAP device will operate just fine and you may not notice anything is off, even the mask seal. However, the air that you are breathing in can and will be contaminated with bacteria and fungus due to the nature of a warm, moisturized internal climate within the CPAP system.
My CPAP is working just fine, why should I clean or replace my equipment?
As I commented above, the equipment will likely be functional which is why over the years countless patients couldn't fathom why we need to replace items more regularly including the mask, hose humidifier and filters.
I'll add this analogy- Do you change your toothbrush every 6-8 months? Do you change your surgical mask every 4-6 hours or do you use the same one? Do you wash your cloth mask regularly or do you wait a month before washing it? They will work the same way but what you don't see is the extraordinarily high accumulation of germs stuck on there that can make you sick. At times there can be a biofilm of bacteria that can grow where we are unable to scrub it off leading to the need of a replacement! Let's get more in to it..
Check out this Harvard Medical School Publication for more information on the risks of dirty CPAP equipment
Replacing your CPAP Accessories
Now-a-days, CPAP machines can have their own reminder systems or your local service provider may be kind enough to remind you about the replacement schedule. Although it may seem like they may want a sale, they are actually just reminding you to take good care of your health! As a rule of thumb, follow the general guideline below or place them on a calendar with a reminder so you don't forget. I've also added some hyperlinks with one of the lowest costs for CPAP supplies across Canada just for you!
Every month
Every 3 months
Every 6 months
- Mask headgear
- Chin strap (if applicable)
-
Humidifier water tub
How often should I clean my CPAP equipment?
As much hassle it seems to be, it doesn't have to be that way! I've listed below in bullet form what the general CPAP cleaning schedule should be:
CPAP Mask:

- Ensure to wipe down your mask on a daily basis with a damp cloth or use the specified CPAP mask wipes made with 100% cotton and powered with Aloe. Do NOT use alcohol or any other wipes on the mask. In my clinical years I had a patient start using make up wipes from the drug store as suggested by a friend. The patient ended up coming in on a monthly for 3 consecutive months because her ResMed F20 CPAP mask cushion kept ripping. Once the patient was educated to use proper CPAP mask wipes, I did not see the patient for another 8 months and the mask was intact!
- On a weekly basis wash the entire mask (Cushion, frame and headgear) in warm soapy water. If HOT water is used, it can deform the silicone and make it more brittle leading to a tear.
- Vinegar is safe to use on the mask for an extra disinfectant.
CPAP Hose:

- Wash your CPAP hose on a weekly basis with warm soapy water.
- The Hose will form a biofilm of bacteria that you will not be able to take off. This happens around the 6 month mark. Again, the hose will remain functional, but the air being breathed in will be getting more contaminated.
CPAP Humidifier:

- CPAP Humidifiers need to be cleaned once per week with warm soapy water.
- An old clean tooth brush and Q-tip will go a long way in helping to get into those tiny cracks and creases!
- Ensure to dump the water at least on a weekly basis and only ever use DISTILLED water to keep your equipment the best it can be.
CPAP Air Filters:
- Ensure to check the user's manual for air filter care. ResMed S9, S10 and S11 machines need to have their filters changed at least every 3-4 months. Unfortunately these filters are unable to be washed. If you do, dirt will start clogging the filter and your motor will wear out faster due to the constraint of air intake.
- Phillips Dreamstation has a reusable filter and a disposable filter. I usually recommend to replace it rather than cleaning it for the same reasons as the Resmed CPAP machines.
CPAP Machine:
- Although we cannot submerge the CPAP machine in water, wiping it down with a cloth on a regular basis will keep your machine looking new for much longer!
Do I need a cleaning machine for my CPAP?
I am sure by now you have heard of automatic CPAP cleaners that will clean your CPAP system for you. Sounds great right? Truth is, it is an option that should be considered by all CPAP users assuming they receive the proper education to make an informed decision. I am not here to say yes or no, I am here to state facts and from there, you make your decision.
Let's start with the definition of cleaning vs. Disinfection:
-
the action of making something clean, especially the inside of a house.
- the act or process of cleansing or purifying a room, wound, item of clothing, etc., of germs that cause disease: After disinfection is complete, the treated water is reintroduced back into the river to support aquatic life, recreation, and downstream drinking water supplies.
Although similar they are different. Think of it as hand washing vs. Hand sanitizing. Hand washing is the act of removing soil and germs from your hands. hand sanitization is the act of killing any live germs on your hands but does not remove it.
Now that we are more familiar with the terms, there are 2 methods in which CPAP cleaners disinfect your equipment:
Ozone (SoClean2)
- the SoClean uses ozone to disinfect the entire system. Creating a closed circuit with the SoClean and the CPAP with its attachments, the ozone gas travels throughout the entire device successfully disinfecting the entire system. It does NOT replace regular cleaning, rather it is used in conjunction with regular cleaning.
- Please note, depending on what machine you have it may be a good idea to check out this article on Ozone use with your CPAP machine.
UVH (Lumin)
- This is a great tool that does not use gas, rather light to disinfect all surfaces that the light can shine on. This includes your humidifier and CPAP mask. The Lumin Bullet would then disinfect the inside of the tubing.
- If you use a Heated CPAP tube, please note your equipment will NOT be compatible with the Lumin Bullet.
I have and will continue to recommend the SoClean or the Lumin for anyone that is vulnerable to frequent pulmonary, sinus or ear infections.
Conclusion
It can definitely be a hassle to keep washing your equipment and even feel wasteful replacing your accessories when you think your therapy is going just fine. However, I hope you remember these pro-tips when it's time to replace your equipment.